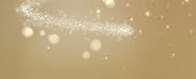
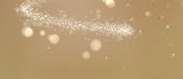

HO-HO-HO! oder NO-NO-NO! Diese Weihnachtsangebote freuen alle ∞ Minuten & SMS 60 GB 5G Daten volumen Ideal Xmas L 29,90€ mtl * 5 Seit Jahren: Weihnachtsfreude ganz nah. 0,-* Details siehe S 04 05 Preisersparnis von 229, gültig bei gleichzeitiger Neuanmeldung eines aktuellen Ideal Xmas SIM Tarifs von Drei Nähere Infos zur Aktion finden Sie unter hartlauer at/dreilights Die angegebenen Stattpreise beziehen sich auf den niedrigsten innerhalb der letzten 30 Tage vor Anwendung der Preisermäßigung von uns verlangten Preises bei Sets die Summe der Einzelverkaufspreise Y72 5G Limitiert auf 333 Stück! Limitiert auf 333 Stück! Details im Rechtstext auf S 05 * X-Mas oder X-Stress? Diese Weihnachtsangebote freuen alle ∞ Minuten & SMS 20 GB 4G Daten volumen Ideal Xmas M 16,90€ mtl * 0,-* Redmi Note 11 t a f 3 3 St ∞ Minuten & SMS Details im Rechtstext auf S 04 * Ideal Xmas SIM M 14,90€ mtl * 35 GB 4G Daten volumen O Tannenbaum oder No Tannenbaum? Auch unsere Weihnachtstarife ohne Bindung freuen alle 50,Statt 279,-*** um nur ** GRATIS Ohne Bindung A P P L E hartlauer.at Gut beraten bei FOTO, HANDY, OPTIK und HÖRGERÄTEN. hartlauer at Dezember 2022 MEIN HANDY-PROFI Alle Serviceleistungen der Mobilfunkanbieter Erstanmeldungen und Vertragsverlängerungen Sprach & Internettarife Verlängern Sie Ihren Vertrag beim Hartlauer Handy-Profi! vereint in jedem unserer 160 Geschäfte. Drei Shop Magenta Shop A1 Shop …bestellenundrechtzeitigbis Weihnachtenerhalten! Bis 18.12. ... MehrabS .31

















































































02 03 Die angegebenen Stattpreise beziehen sich auf den niedrigsten, innerhalb der letzten 30 Tage vor Anwendung der Preisermäßigung von uns verlangten Preises, bei Sets die Summe der Einzelverkaufspreise Die beworbenen Produkte sind nicht in jedem Geschäft lagernd auf Bestellung erhältlich Abgabe der Ware erfolgt nur in Haushaltsmengen Gültig solange der Vorrat reicht Die Angabe der verfügbaren Speicherkapazitäten ist aufgrund der Mobiltelefon Software geringer Druck und Satzfehler vorbehalten Die dargestellten Preise sind per 30 11 gültig und können sich ändern Die tagesaktuellen gültigen Preise finden Sie in Ihrem Hartlauer Geschäft oder online unter www hartlauer at Individuelle Freude schenken! Mehr auf hartlauer.at/gutscheincards FROHE WEIHNACHTEN Für Sie und Ihre Liebsten zum Fest der Freude! Einfach MEHR … Hartlauer Ruck Zuck Fotobuch Mehr auf hartlauer.at/ruckzuck In nur 5 Minuten am Smartphone gestalten! h Jetzt App downloaden! 8,, ab ULTRA® MICROSDXC™ UHS I 512 GB | 120 MB/S SPEICHERKARTE MEHR AUFNEHMEN & SPEICHERN • Ideal für Android Smartphones und Tablets • Übertragungs geschwindigkeiten von bis zu 120 MB/s -19% AKTION STATT 79,95* NUR 64,64, Smartwatch für Fortge schrittene GEN 6 WELLNESS SILIKON SMARTWATCH 2X SCHNELLER LADEN • 3,3 cm AMOLED Touchdisplay • Qualcomm® Snap dragon Wear™ 4100+ NEU O 299,99, GRATIS Fossil Armband Val Mosaic Disc Perlmutt im Wert von 65, Smartwatch für Anfänger SMARTWATCH SMARTWATCH STETS AM PULS DER ZEIT • 1,3“ Touchscreen • Einfache Navigation • Pulsmessung am Handgelenk 33,33 NEU Smartwatch für Fortge schrittene IGNITE 3 SMARTWATCH ZEIT, AUFZUSTEHEN • 1,28“ AMOLED Display • 120 Stunden Akku laufzeit im Uhrmodus 329,95 EBERTON II BLUETOOTH LAUT LEGENDÄRER SOU • 2“ Breitbandlaut • 30h Spieldauer • 3h Ladezeit • Bluetooth 5 1 TSPRECHER ND sprecher 169,545,RS 3 GIMBAL JEDERZEIT BEREIT • Nur 1,3kg • 1,8“ OLED Touchscreen • Schnellwechselplatten • Drahtlose Verschluss Steuerung Smartwatch für Fortgeschrittene NEU WATCH D SMARTWATCH LEICHTES & KOMFORTABLES DESIGN • Blutdruckmessung: Mini pumpe und Luftkissen für genaue Messungen unterwegs 399,399, OM-D E-M 10 MARK IV + 14-42/3,5-5,6 EZ SYSTEMKAMERA SET KOMPAKT UND LEISTUNGSSTARK • 20MP Live MOS Sensor • 5 Achsen Bildstabilisation • 180° Flip Touch Screen 849,849, E Nicht in allen Geschäften lagernd 64GB CRUZER GLIDE USB 3.0 USB STICK SPEICHERN SIE IHRE ERINNERUNGEN • Schnelle USB 3 0 Leistung, weniger Wartezeit • Zuverlässiger Speicher bis zu 128GB für alle Dateien -39% AKTION STATT 14,95* NUR 9,9,












































































































hartlauer.at Gut beraten bei FOTO, HANDY, OPTIK und HÖRGERÄTEN. MEIN HANDY PROFI Seit Jahren: Weihnachtsfreude ganz nah. BAT 05A + VX20 KIT ALU STATIV KAMERASTATIV IMMER UND ÜBERALL EINSATZBEREIT • 5 voreingestellte Beinwinkel • Max Höhe 141,3cm • Max Höhe ohne Mittelsäule 111cm • Tragfähigkeit 10kg -12% ROOMBA j7+ SAUGROBOTER MIT ABSAUGSTATION UNVERGLEICHLICHE SAUBERKEIT • Hinderniserkennung • 3 Stufen Reinigungssystem • Sprachassistent kompatibel • Lithium Ionen Akku 849,g Erhältlich im Hartlauer Plus Sortiment: jetzt auf hartlauer at oder im Geschäft bestellen! UC 5620 ULTRASCHALLREINIGER HOCHEFFIZIENTE REINIGUNG • Geeignet für: Brillen und Schmuck, Rasierköpfe, Besteck, Zahnbürsten, Zahnersatz, Zahnspangen, Schmuck, wasserdichte Uhren, Kämme u v m 29,Noch mehr Auswahl finden Sie auf hartlauer.at/we … Geschenkhighlig FTW4059 GEN 6 SMARTWATCH VIEL MEHR, VIEL SCHNELLER • 44mm Gehäuse • Schnelle Ladezeit (80% in ca 30min) -24% Smartwatch für Fortge schrittene AKTION STATT 329, * NUR 249,AKTION STATT 79,95* NUR 69,95 269,- Dual-SIM 64MP+8MP+5MP+5MP Quad Hauptkamera 20MP Frontkamera OFFEN FÜR ALLE NETZE STARKE PERFORMANCE • 6,4“ (16,3cm) FHD+ Super AMOLED Display mit 90Hz ALPHA 6000 + OBJEKTIV 16 50MM/3,5 5,6 OSS SYSTEMKAMERA SET ÖSTERREICHS BELIEBTESTE SYSTEMKAMERA • Geniale 24MP Qualität TT350 BLITZGERÄT MOTIVE, PERFEKT IN SZENE GESETZT • Klein und kompakt • Reichweite 30 Meter • Full TTL Funktionen: Unterstützt HSS (max 1/8000s) • Erhältlich für Nikon, Sony, Canon, Fujifilm & Olympus/OM System Nicht in allen Geschäften lagernd 89,95 PROSTAFF 7S 10X42 FERNGLAS EIN FERNGLAS DER EXTRAKLASSE • Hohe Auflösung dank phasenkorrigierter Vergütung • Besonders leichte Konstruktion Nicht in allen Geschäften lagernd 209,95 Nicht in allen Geschäften lagernd 219,95 OSMO MOBILE 6 SMARTPHONE GIMBAL MAGNETISCHE MOMENTE KREIEREN • 3 Achsen Stabilisierung • Schnellstart • Handlich und faltbar • ActiveTrack 5 0 • Einfache Tutorien & Nachbearbeitung Smartphone nicht inkludiert 169,VEO GO 42M RUCKSACK KLASSISCH STYLISCHER, SCHLANKER RUCKSACK • VEO 2 GO Stativanschluss • Sicherer Zugang von hinten • Rundum gut gepolstert • Bietet Platz für ein 9,7“ Tablet • Ideal für System kamera oder Drohne Nicht in allen Geschäften lagernd 99,95 Nicht in allen Geschäften lagernd 499,CO2 MESSGERÄT PRÄZISE MESSUNG • Intelligente Kalibrierung • Farbdisplay mit Einstufung der Luftqualität • Temperaturanzeige • Feuchtigkeits anzeige • Datum und Uhrzeitfunktion MINI MASSAGEGUN MASSAGEGERÄT FÜR DAS SPA FEELING IM ALLTAG • Lockert die Muskulatur • Fördert die Blutzirkulation • Gummierter Griff liegt angenehm in der Hand • 6 Massageköpfe für verschiedene Körperpartien 59, , 95 9 Inkl Tasche perfekt für die Aufbewahrung und Mitnahme eihnachten hts!






















04 05 Stattpreiserklärung siehe S 02 03 Bis zu -10% Leos-Sofortrabatt Mehr auf hartlauer.at/loewenclub ∞ Minuten & SMS Ideal Xmas SIM M 14,90€ mtl * 35 GB 4G Daten volumen 27 € Servicepauschale / Jahr Kein Aktivierungsentgelt Bei Neuanmeldung ohne Mindestvertragsdauer Details: drei at/xmas * O Tannenbaum oder No Tannenbaum? Auch unsere Sim only Weihnachtstarife ohne Bindung freuen alle m. € mtl. * *Aktion gültig bei Neuanmeldung zu einem Ideal Xmas SIM Tarif und nur solange der Vorrat reicht Details: hartlauer at/dreilights VORTEILE Löwenstarke Hartlauer Handy-Profi: Drei Shop, Magenta Shop & A1 Shop vereint Limitiert auf 333 Stück Y72 DREI NIEMALS DEN FOKUS VERLIEREN 50,50 *








































































hartlauer.at Gut beraten bei FOTO, HANDY, OPTIK und HÖRGERÄTEN. MEIN HANDY-PROFI Seit Jahren: Weihnachtsfreude ganz nah. REDMI NOTE 11 4G DREI SCHARF UND KONTRASTREICH Y76 DREI GROSSARTIGES DESIGN 0,-* um ∞ Minuten & SMS Ideal Xmas M 16,90€ mtl * 20 GB 4G Daten volumen 27 € Servicepauschale / Jahr Bei Neuanmeldung mit 24 Monaten Mindestvertragsdauer 3 € URA / Smartphone Details: drei at/xmas * *Bei Neuanmeldung zum Tarif Ideal Xmas M mit 24 Monaten Mindestvertragsdauer 27 € Servicepauschale / Jahr 3 € URA / Smartphone Details: hartlauer at/drei um 0,0, * GALAXY S22 5G DREI BEGLEITER FÜR ÜBERALL 128GB DREI EXTREM ROBUST 342,-* um 5G Daten volumen ∞ ∞ Minuten & SMS 27 € Servicepauschale / Jahr Bei Neuanmeldung mit 24 Monaten Mindestvertragsdauer 3 € URA / Smartphone Details: drei at/xmas * Ideal Xmas Unlimited 49,90€ mtl * *Bei Neuanmeldung zum Tarif Ideal Xmas Unlimited mit 24 Monaten Mindestvertragsdauer 27 € Servicepauschale / Jahr 3 € URA / Smartphone Details: hartlauer at/drei um 0,0 * ∞ Minuten & SMS Ideal Xmas L 29,90€ mtl * 60 GB 5G Daten volumen *27 € Servicepauschale / Jahr Bei Neuanmeldung zum Tarif Ideal Xmas L mit 24 Monaten Mindestvertragsdauer 3 € URA / Smartphone Details: hartlauer at/dreilights Alle Vorteile Erstanmeldungen und Vertragsverlängerungen Sprach & Internettarife Apple iPhone 14 GALAXY A53 5G DREI ALLES, WAS DU BRAUCHST GALAXY WATCH 4 DREI EINZIGARTIGER LOOK + GRATIS Im Wert von 199, zum Mindestvertragsdauer. URA Smartphone. 0,0, * um Limitiert auf 333 Stück





























































































































































































06 07 Stattpreiserklärung siehe S 02 03 Individuelle Freude schenken! Mehr auf hartlauer.at/gutscheincards FROHE WEIHNACHTEN 5 MONATE GRUNDGEBÜHR G OHNE Aktivierungsentgelt Bis zu 5 MONATE GRUNDGEBÜHR GRATIS* Wechsle jetzt und surfe noch schneller mit zuverlässigem WLAN6. Das ist #UmMagentaBesser *Zzgl Servicepauschale € 29,99 jährlich Aktion Rabattierung der mtl Grundgebühr (GGB) auf € 0 für die ersten 5 Monate in Tarifen mit einer max Bandbreite von über 100 Mbit/s (Download) sowie Aktion “kein Aktivierungsentgelt” (statt € 39,99) gültig für Neukunden bei Bestellung bis auf Widerruf (ausgenommen Hi!Magenta,Tarife mit Jugendbonus sowie Tablet Internet) 24 Monate Mindestvertragsdauer Danach reguläre mtl GGB des gewählten Tarifs lt Entgeltbestimmungen zum Zeitpunkt derAnmeldung (z B gigakraft 250 um € 42 mtl ) Technische Verfügbarkeit vorausge setzt WLAN 6 Routerin allen Magenta Kabel Internettarifen inkludiert und auch in Magenta Flex und 5G Internettarifen zwischen einmalig € 0 und max € 249 verfügbar (abhängig vom gewählten Tarif, ausgenommen Magenta Internet Fix Tarife auf DSL Basis) Preise und Details auf magenta at KOMBINIER & KASSIER MagentaEINS Monatlich bis zu € 10 MagentaEINS Bonus Jetzt Magenta Smartphone Tarif und BREITERBAND Internet kombinieren und von allen MagentaEINS Vorteilen profitieren. Alle Voraussetzungen zu MagentaEINS unter www magenta at/magentaEINS VORTEILE Löwenstarke Hartlauer Handy-Profi: Drei Shop, Magenta Shop & A1 Shop vereint





















































































































































































































































































































































































































































































































































































































































































































































hartlauer.at Gut beraten bei FOTO, HANDY, OPTIK und HÖRGERÄTEN. MEIN HANDY-PROFI Seit Jahren: Weihnachtsfreude ganz nah. 128GB MAGENTA BEEINDRUCKENDE AUFNAHMEN GALAXY S22 MAGENTA EIN AKKU, DER VIEL DRAUFHAT 0,-* um Mobile Unlimited Gold unlimitierteGB um €64* mtl KeinAktivierungsentgelt *Zzgl Servicepauschale € 33 jährlich Ur heberrechtsabgabe € 3 Smartphone An gebotegültigimTarifMobileUnlimitedGold 24 Monate Mindestvertragsdauer Derzeit ist 5G örtlich nur eingeschränkt verfügbar um 0,0, * GALAXY A53 5G MAGENTA PLATZ FÜR KOSTBARE MOMENTE REDMI NOTE 11S 5G MAGENTA AUFREGENDE DYNAMIK 0,-* um Mobile S 20GB UnlimitedWeekend um €29* mtl KeinAktivierungsentgelt. *Zzgl Servicepauschale € 33 jährlich Ur heberrechtsabgabe € 3 Smartphone An gebote gültig im Tarif Mobile S 24 Monate Mindestvertragsdauer Unlimited Weekend ermöglichtunlimitiertenDatenverbrauchim InlandohneAnrechnungaufdasDatenvolu men jedes Wochenende zwischen Freitag, 18 Uhr bis Sonntag, 24 Uhr Derzeit ist 5G örtlichnureingeschränktverfügbar um 0,0, * A57S MAGENTA QUALITÄT ZUM KLEINEN PREIS GALAXY A23 MAGENTA JEDE NUANCE VON „WOW“ 0,-* um 0,0, * um VON Hi!Magenta Smartphone Aktion 40GB um €19* mtl *Zzgl. Servicepauschale € 27 jährlich. Urheberrechtsabgabe € 3. Smartphone Angebot gültig im Tarif Hi!Magenta Smartphone mit 24 Monaten Mindestvertragsdauerbis aufWiderruf Alle Vorteile Erstanmeldungen und Vertragsverlängerungen Sprach & Internettarife Apple iPhone 14






























08 09 Stattpreiserklärung siehe S 02 03 Bis zu -10% Leos-Sofortrabatt Mehr auf hartlauer.at/loewenclub 0 O € BONUS Jährliches Entgelt: € 34,90/Jahr Angebot: Nach Wahl des Kunden 100 Euro Bonus (Rechnungsgutschrift auf einer der ersten Rechnungen) oder gratis Tablet (A1 Alpha Pad 10 oder gleichwertiges Gerät) gültig bei Bestellung von A1 Internet ab 100 Mbit/s oder A1 Glasfaser Internet Tablet muss binnen eines Monats nach Herstellung separat angefordert werden, andernfalls erlischt der Anspruch darauf Sollte die Herstellung aus nicht von A1 verschuldeten Gründen nicht spätestens 3 Monate nach Bestellung erfolgt sein, erlischt der Anspruch auf das Tablet Gratis Herstellung (bei erforderlichem Techniker:innen-Einsatz oder Selbstinstallation) bei Tarifen ab 100 Mbit/s, sonst € 49,90. Mindestvertragsdauer 24 Monate. Angebot gültig für A1 Breitband-Neukunden bis auf Widerruf und solange der Vorrat reicht Details auf A1.net €100,- Bonus oder Gratis-Tablet sichern! Zu jedem A1 Internet-Tarif ab 100 Mbit/s. Jetzt Du Im A1 Giganetz Gratis Herstellung Jetzt Du Im A1 Giganetz. 5G für Österreich –jetzt in allen A1 X-Mas Tarifen. Doppelte Daten Gratis Aktivierung Mobile Service Pauschale € 34,90/Jahr * Aktionskonditionen gültig für A1 Internet Kunden (ansonsten monatlich € 22,90 mit 16 + 16 GB Datenvolumen) bei Neuanmeldung zu A1 SIMply X Mas S bis 06 02 2023, danach gilt das reguläre Datenvolumen gemäß Entgeltbestimmungen Entfall Aktivierungsentgelt iHv € 49,90 A1 Internet Kunden: Es gelten die A1 Connect Plus Bedingungen ( € 4, monatlich und + 4 GB zusätzliches Datenvolumen) Details auf A1 net VORTEILE Löwenstarke Hartlauer Handy-Profi: Drei Shop, Magenta Shop & A1 Shop vereint











































































hartlauer.at Gut beraten bei FOTO, HANDY, OPTIK und HÖRGERÄTEN. MEIN HANDY-PROFI Seit Jahren: Weihnachtsfreude ganz nah. A33 5G A1 EDITION LÄSST SICH NICHT UNTERKRIEGEN Y52S 5G A1 EDITION EIN ECHTES „GROSSFORMAT“ GEFÜHL 79,-* um
nect Plus Bedingungen Details auf A1 net A1 Mobil X Mas S 15GB In Österreich und EU gültig 5 000 Minuten, SMS & MMS €2290 Mntl Grundentgelt mit A1 Connect Plus +10GB im Monat geschenkt Gratis Aktivierung um 149,149, * GALAXY A53 5G A1 EDITION ACTIONGELADENE VIDEOS KEIN PROBLEM! A1 Xcite X Mas S für Österreich in allen Xcite X MAS Tarifen 35GB Mit Top 5G Smartphones Gratis Aktivierung €1990 Monatliches Grundentgelt
Speichermedienvergütung € 3 / Mobiltelefon Zusendung erfolgt frühestens 14 Tage nach SIM Aktivierung bei Nichtaktivie rung nach 1 Monat erlischt der Anspruch An gebot gültig bis auf Widerruf bzw nur solange der Vorrat reicht Alle Preise in € inkl USt um 199,199, * GALAXY A13 5G RED BULL MOBILE FASZINIERENDES DISPLAY Y22S 5G RED BULL MOBILE PLATZ FÜR ERINNERUNGEN 0,0, * um S Unlimitierte Minuten & SMS max 100 MBit/S Down & 20 MBit/S Upload Core M b l S i P h l €34 90/J h Akt v erungsentge t entfäl Spe chermed envergütung € 3 / Mob te efon Beworbener Gerätepre s bei Neuan d g d b b T d 24 M t b d g Angegebene Geschw nd gke ten ste len techn sche Max ma geschw nd gke ten dar D t i f db bi t/ €18,90 im Monat Gratis Aktivierung Datenvolumen um 0,0, * Alle Vorteile Erstanmeldungen und Vertragsverlängerungen Sprach & Internettarife Jetzt OliverNotebook gratis
Mobile Service Pauschale € 34,90/Jahr Aktionskonditionen gültig für A1 Internet Kunden (ansonsten monatlich €27 90 mit 15 GB Datenvolumen) bei Neuanmeldung zu A1 Mobil X Mas S bis 06 02 2023 Entfall Aktivierungsentgelt iHv € 49,90 Vertrags bindung 24 Monate Es gelten die A1 Con
Mobile Service Pauschale € 34,90/Jahr Zu A1 Mobile Xcite S und L Anmeldung erhal ten Neukunden ein gratis Oliver Book A1 (oder gleichwertig) Vertragsbindung 24 Mo nate Anmeldbar bis zum vollendeten 26 Le bensjahr








































































VORTEILE Löwenstarke Hartlauer Handy-Profi: Drei Shop, Magenta Shop & A1 Shop vereint 10 11 Stattpreiserklärung siehe S 02 03 Individuelle Freude schenken! Mehr auf hartlauer.at/gutscheincards FROHE WEIHNACHTEN 0,0, * um um 0,0, * Hartlauer Handy-Profi: Drei-Shop, Magenta-Shop, A1-Shop & MTEL-Shop vereint GALAXY A13 64GB MTEL ...BIRNE? 64GB MTEL APFEL ODER Apple iPhone 11 Profitieren Sie von den individuellen Vorteilen aller großen Netzanbieter und das mit unabhängiger Beratung vom Hartlauer Handy-Profi. In Ihrer Nähe 160x in Österreich! Alle e alle Vo o Handy Profi Vorteile, alles vom Handy-Profi Alle Services entdecken auf hartlauer.at/services HARTLAUER AT/MTEL
•
•
•
• Ultraschneller
•
iPhone 14
OFFEN FÜR ALLE NETZE











IPHONE 14. EIN
















































RIESIGER






SCHRITT NACH VORNE

• 6,1“ Super Retina XDR Display

































• Fortschrittliches Kamera System für bessere Fotos bei jedem Licht
• Kinomodus jetzt in 4K Dolby Vision mit bis zu 30 fps
• Action Modus für ruckelfreie, frei gefilmte Videos
• Ein wichtiges Sicherheitsfeature: die Unfallerkennung, ruft Hilfe, wenn Sie es nicht können
und Apple Pay
• Machen Sie einfach weiter mit Batterie für den ganzen Tag
Alle Vorteile Erstanmeldungen und Vertragsverlängerungen Sprach & Internettarife A P P L E A P P L E A P P L E A P P L E A P P L E A P P L E A P P L E A P P L E hartlauer.at Gut beraten bei FOTO, HANDY, OPTIK und HÖRGERÄTEN. Details zur Santander 0% Finanzierung auf Seite 12 Bei Einlösung von 10 000 Leos Mehr auf hartlauer at/loewenclub MEIN HANDY-PROFI Seit Jahren: Weihnachtsfreude ganz nah. uzsiBklusivfür enclub-Mitglieder S ZU-10% ** 999,B 539,539, Version 45mm 12MP Backkamera 7MP Frontkamera OFFEN FÜR ALLE NETZE SUPERSTARK. AUCH BEIM PREIS • 4,7“ Retina HD Display • A15 Bionic Chip mit 4 Core GPU • Bis zu 15h Videowiedergabe • 5G Mobilfunk • Robustes Design und Wasserschutz iPhone SE (2022) 12MP Backkamera 7MP Frontkamera 619,128GB 429,64GB AirPods MacBook Air 13“ Apple Watch Series 8 3. GENERATION KOPFHÖRER EINFACH NOCH MAGISCHER • Personalisiertes 3D Audio mit dynamischem Head Tracking sorgt für Sound überall um dich herum SMARTWATCH EIN GESUNDER SPRUNG NACH VORN • Misst den Sauerstoffgehalt in Ihrem Blut mit einem leistungsstarken Sensor und einer App • Machen Sie ein EKG jederzeit, überall NOTEBOOK MACBOOKAIR. MIT DER POWER DES M • M1 Chip für unglaubliche Performance bei CPU, GPU und maschinellem Lernen • 18h Batterielaufz reichen für den ganzen Tag xklusivfür Löwenclub-Mitglieder BIS 9. GENERATION TABLET DAMIN KÖNNEN SIE ALLES. SOGAR WENIGER AUSGEBEN.
10,9“ Retina Display mit True Tone
Chip
Neural Engine
Touch
Authentifizieren
•
• A13 Bionic
mit
•
ID für sicheres
8MP Backkamera 12MP
iPad OFFEN FÜR ALLE NETZE
Frontkamera
IPHONE 13. IHRE NEUE SUPERPOWER
6,1“Super Retina XDR Display
A15 Bionic Chip mit 4 Core GPU
5G
Mobilfunk
Bis zu 19h Videowiedergabe
zum Personalisieren, Kommunizieren und Teilen 12MP+12MP Dual Backkamera 12MP Frontkamera iPhone 13 219,95 1.129,1.129 Batterielaufzeit oder zu 36 Monatsraten á 27,75* 899,899128GB oder zu 36 Monatsraten á 24,97*
iOS 16 gibt Ihnen noch mehr Möglichkeiten
•
ALLES, WAS SIE BRAUCHEN































































•

•






• 5.000mAh







•
FÜR ALLE NETZE
•
•
VORTEILE Löwenstarke FROHE WEIHNACHTEN h t Ein Geschenk mit einfach MEHR Auswahl! Gutscheincards erhältlich im Geschäft & auf hartlauer at/gutscheincards uzsiBExklusivfür Löwenclub-Mitglieder BISZU-10% * 12 13 Repräsentatives Berechnungsbeispiel für eine Ware mit einem Kaufpreis von € 1 000 : Gesamtkreditbetrag € 1 000 ; Laufzeit 36 Monate; 0% p a Soll und Effektivzinssatz; Rate € 27 78/Monat; zu zahlender Gesamtbetrag € 1 000 ; Bankübliche Bonitätskriterien vorausgesetzt Die Finanzierungsentscheidung obliegt unserer Partnerbank der Santander Consumer Bank GmbH Nähere Infos auf hartlauer at/finanzierung Die Samsung Cashback Aktion gilt für alle teilnehmenden Produkte von 29 11 2022 bis 15 01 2022 in allen Hartlauer Geschäften und im Hartlauer Onlineshop Der Kauf muss im Aktionszeitraum unter cashback samsung at registriert werden Nach erfolgreicher Prüfung wird Ihnen der vom Produkt abhängige Cashback Betrag direkt von Samsung auf Ihr Konto überwiesen Details auf hartlauer at/samsungcashback Bis zu -10% Leos-Sofortrabatt Mehr auf hartlauer.at/loewenclub OFFEN FÜR ALLE NETZE IHR ESSENZIELLER BEGLEITER • 6,4“ FHD+ Super AMOLED Display mit 90Hz • 64Bit 5nm Octa Core Prozessor
128GB interner Speicher
5 000mAh Akku mit 25W Super Schnellladen Dual SIM 48MP+8MP+5MP+2MP Quad Hauptkamera 13MP Frontkamera Dual SIM 50MP+5MP+2MP+2 Quad Hauptkamera 8MP Frontkamera 329,OFFEN
•
•
FÜR ALLE NETZE
6,5“ FHD+ Super AMOLED Display mit 120Hz
11“ WQXGA LTPS
Display
TFT 120Hz
mit 25W Super Schnellladen
IP67 staub und wasserresistent Dual SIM 64MP+12MP+5MP+5MP Quad Hauptkamera 32MP Frontkamera OFFEN
TAFF WIE
BUSINESS
•
SO
IHR
5,3“ HD+ Display, bedienbar sogar
und
mit Handschuhen
bei Feuchtigkeit
4GB RAM/64GB ROM
3
000mAh Akku, wechselba
MIL STD
IP68 Zertifizierung OFFEN FÜR ALLE NETZE LEISTUNG, DIE VIEL AUF EINMAL MÖGLICH MACHT • 6,6“ FHD+ PLS TFT Infinity V Display mit 120Hz • Leistungsstarker 5 000mAh Akku für eine lange Laufzeit • 64GB interner Speicher • Quad Kamera für vielseitige Aufnahmen wechselbar Dual SIM 16MP Hauptkamera 5MP Frontkamera 279,279, 279,279 179,179, OFFEN FÜR ALLE NETZE FOKUS AUF DAS WESENTLICHE • 6,5“ HD+ PLS TFT Infinity V Display mit 90Hz • 32GB interner Speicher • Android 12 Dual SIM 50MP+2MP+2MP Triple Hauptkamera 5MP Frontkamera 199,199 OFFEN FÜR ALLE NETZE DAS SMARTPHONE FÜR SIE • 6 6“ FHD+ PLS TFT Infinity V Display • 4 GB RAM, 64 GB Speicher • 5000 mAh Akku mit Fast Charging Technologie • Seitlicher Fingerabdrucksensor 50MP+5MP+2MP+2MP Quad Hauptkamera 8MP Frontkamera Dual SIM 399,oder zu 36 Monatsraten á 11,08**
• Widerstandsfähig dank
810H und























































































Keine Kosten oder Gebühren 0,0% eff.p.a, Laufzeit: 36 Monate** 0% Finanzierung ab 100,- Auchim Onlineshop ! hartlauer.at/finanzierung hartlauer.at Gut beraten bei FOTO, HANDY, OPTIK und HÖRGERÄTEN. MEIN HANDY-PROFI Seit Jahren: Weihnachtsfreude ganz nah. Stattpreiserklärung siehe S 02 03 Bei Einlösung von 10 000 Leos Mehr auf hartlauer at/loewenclub 13MP+6MP Dual Hauptkam 12MP Frontkamera OFFEN FÜR ALLE NETZE BEREIT FÜR MEHR KREATIVITÄT • 6,1“ FHD+ Dynamic AMOLED 2X Infinity O Flat Display • 3 700mAh Akku mit 25W Super Schnellladen • Intelligente Triple Kamera • IP68 staub und wasserresistent 50MP+10MP+12MP Triple Backkamera 10MP Frontkamera Dual SIM OFFEN FÜR ALLE NETZE DIE WELT AUS JEDEM WINKEL • 6,7“ FHD+ Dynamic AMOLED 2X Infinity O Display • 1,9“ Super AMOLED Cover Display • Kratzfestes Corning® Gorilla Glass® Victus+TMund • gepanzertes Aluminium • Wasserfest dank IPX8 Zertifizierung OFFEN FÜR ALLE NETZE PRODUKTIVITÄT, KREATIVITÄT UND ENTERTAINMENT IN E • 11“ WQXGA LTPS TFT Display mit 120Hz • 4nm 64 bit Octa Core Prozessor • 8GB Arbeitsspeicher • 128GB interner Speicher • 8 000 mAh mit 45W Super Schnellladen 12MP+12MP Dual Backkamera 10MP Frontkamera Dual SIM OFFEN FÜR ALLE NETZE AUSDAUERNDER A FÜR LANGE TAGE • 6,8“ QHD+ Dynam AMOLED 2X Infin O Edge Display • 5 000mAh Akku mit 45W Super Schnellladefunkt 108MP+12MP 10MP+10MP Quad Haupt 40MP Frontk Dual SIM N A E AKKU Dynamic Infinity Schnellladefunktion 108MP+12MP+ Hauptkamera Frontkamera Jetzt Cashback holen! oder Zum Beispiel 190 € Cashback beim Kauf eines Galaxy Z Flip4 zusammen mit der Galaxy Watch5 + 150 € Cashback beim Kauf eines Galaxy Z Flip4 Bildsimuliert Aktiongültigbis3112 2022 DieHöhedesCashbackBetragesistabhängigvomgekauftenModell AlleDetailsunterhartlauerat/samsungcashback EINEM Inkl. smartem S Pen für all Ihre Ideen & Skizzen 1.249,1.249, abzgl. 150, Cashback 1099, *** 1.099,, abzgl. 150,- Cashback 949,-*** 749,749, abzgl. 100,- Cashback 649,-*** 829,829, abzgl. 100, Cashback 729, ***
























































































































































SERVICES Löwenstarke X I A O M I X I A O M I X I A O M I X I A O M I X I A O M I X I A O M I Einfach MEHR Ersteinrichtungsservices für Smartphones, Tablets & Co hartlauer at/smartstart 14 15 Stattpreiserklärung siehe S 02 03 Bei Einlösung von 10 000 Leos Mehr auf hartlauer at/loewenclub Details zur Santander 0% Finanzierung auf Seite 12 Individuelle Freude schenken! Mehr auf hartlauer.at/gutscheincards FROHE WEIHNACHTEN 249,Version 46mm Dual SIM 50MP+2MP Dual Backkamera 5MP Frontkamera REDMI 9A 4G 32GB OFFEN FÜR ALLE NETZE NEUER EDLER LOOK • 6,53“ (16,5cm) HD+ Display • MediaTek Helio G25 Prozessor • 5 000mAh Akku • Android Dual SIM 13MP Backkamera 5MP Frontkamera MI BODY COMPOSITION SCALE 2 KÖRPERANALYSEWAAGE PRÄZISERE MESSUNG • Erkennt Gewichtsänderung bis 50g • Einfache Messung des Körperfettanteils • Gleichgewichtstest • 13 Metriken zur Körperzusammensetzung XIAOMI WATCH S1 SMARTWATCH ELEGANZ UND FITNESS VEREINT • 1,43“ AMOLED Display • Wasserbeständig bis 5 bar • 117 Trainingsmodi, darunter 19 professionelle Trainingsmodi • 470 mAh Akku REDMI NOTE 11S 128GB OFFEN FÜR ALLE NETZE INTELLIGENTER UND PRAKTISCHER • 6,43“ (16,3cm) Flat AMOLED Display • 90Hz Bildwiederholrate • Octa Core MediaTek Helio G96 Dual SIM 108MP+8MP+2MP+2MP Quad Backkamera 16MP Frontkamera P F REDMI 10C 64GB OFFEN FÜR ALLE NETZE SMART AUF GANZER EBENE • 6,71“ Dot Drop Display • Snapdragon 680 • 4GB RAM/64GB ROM • Bluetooth 5 0 XIAOMI 12 LITE OFFEN FÜR ALLE NETZE MEIN STYLE. MEIN SHOT. • 6 55“ AMOLED Dot Display • Snapdragon 778G • 4 300mAh Akkukapazität • MIUI 13 mit Android 12 • 67W Turbo Charge 108MP+8MP Triple Backk 32MP Frontk P a F 169,- 139,139 34, , 95 117 darunter STATT 279, * NUR 259,Smartwatch für Fortgeschrittene 469,469 oder zu 36 Monatsraten á 13,03***



































































































VORTEILE Löwenstarke Zusätzlich beim Kauf eines Smartphones 15% auf Zubehör sparen! A L E X A N D R A U N S E R M E H R A N W I S S E N : „ Das schnelle Vivo Y72 hält Ihre kostbaren Momente perfekt fest und begeistert mit vielen Bildbearbei tungsfunktionen sowie einem ausgefallenen Design, wie z B Dream Glow und 3D Ecken ideal für den Alltag hartlauer.at Gut beraten bei FOTO, HANDY, OPTIK und HÖRGERÄTEN. MEIN HANDY-PROFI Seit Jahren: Weihnachtsfreude ganz nah. Y72 5G OFFEN FÜR ALLE NETZE SCHLANK UND RAFFINIERT • 6,58“ IPS Display • 8GB RAM/128GB ROM • 5 000mAh Akku uzsiBExklusivfür Löwenclub-Mitglieder BIS-10% ** uzsiBExklusivfür Löwenclub-Mitglieder BISZU-10% ** Y33S OFFEN FÜR ALLE NETZE EINFACH ELEGANT • 6,58“ LCD Display • 10 fach Zoom • 128GB interner Speicher 50MP+2MP+2MP Triple Backkamera 16MP Frontkamera Y76 5G 128GB OFFEN FÜR ALLE N HERAUSRAGENDES DESIGN • 8GB RAM + 4GB erweiterter RAM • 4 100mAh Akku + 44W Schnellladun 50MP+2MP+ Triple Backkamera 16MP Fron klusivfür Löwenclub-Mitglieder Y21 64GB OFFEN FÜR ALLE NETZE HANDLICHES SELFIE WUNDER • 6,51“ HD+ Halo Fullview Display • 5 000mAh Akku + 18W Schnellladung • Funtouch OS 11.1 • RAM 4GB/ROM Dual SIM 13MP+2MP Dual Backkam 8MP Frontkam 229,NETZE Schnellladung P Frontk Backkamera Frontkamera 169,299,299 369,ZU 64MP+8MP+2MP Triple Backkamera 44MP Frontkamera Dual SIM 259,oder zu 36 Monatsraten á 7,19*** 64MP+8MP+2MP Triple Backkamera 16MP Frontkamera Dual SIM V21 5G OFFEN FÜR ALLE NETZE ERHELLT DIE NACHT • 6,44‘‘ AMOLED Display • 10 fach Zoom • Selfies mit optischer Bildstabilisierung
•
•
•
•
•

















































































































































Auchim Onlineshop ! 16 17 *Stattpreiserklärung siehe S 02 03 Bei Einlösung von 10 000 Leos Mehr auf hartlauer at/loewenclub Details zur Santander 0% Finanzierung auf Seite 12 Bis zu -10% Leos-Sofortrabatt Mehr auf hartlauer.at/loewenclub MATEPAD T10 TABLET DAS TABLET FÜR ALLES • 9,7“ IPS HD Display • Octa Core Prozessor • eBook Modus • 64GB interner Speicher • GSpace App: für alle Google Dienste wie Google Maps 5MP Backka 2MP Frontk a uzsiBExklusivfür LöwenclubMitglieder BISZU-10% ** NOVA Y70 OFFEN FÜR ALLE NE VOLLE KRAFT VORAUS • 6 000mAh Akku • 6,75“ HUAWEI • FullView Display • 128GB interner Speic • 22,5W HUAWEI SuperCharge • GSpace App: für alle Dienste wie Google M 48MP+5MP+2 Triple Backka 8MP Frontkam Dual SIM NOVA 9 SE OFFEN FÜR ALLE NETZE TOLLE NACHTAUFNAHMEN • Hochauflösende 108MP Kamera •
bis zu 90Hz
6,78“ FHD+ Display mit
Bildaktualisierungsrate
128GB interner Speicher
66W HUAWEI SuperCharge
Maps 108MP+8MP+2MP+2MP Hauptkamera 16MP Frontkam Dual SIM NETZE Speicher Google Maps P Frontk
GSpace App: für alle Google Dienste wie Google
ALLE NETZE
NOVA Y90 OFFEN FÜR
DAS FUNKELN IN IHREN AUGEN
6,7“ FHD Display
50MP Triple Kamera • 40W HUAWEI SuperCharge • 128GB interner Speicher • GSpace App: für alle Google Dienste wie Google Maps 50MP+2MP+2MP Triple Backkamera 8MP Frontkamera Dual SIM NOVA 10 OFFEN FÜR ALLE NETZE NEUE VISION, NEUE WELT • 60MP Ultraweitwinkel Frontkamera • 6,67‘‘ FHD+OLED Display • Ultraschlankes und leichtes Design
66W HUAWEI SuperChar • GSpace App: für alle Goog Dienste wie Google Maps 50MP+8MP+2MP Triple Backkamera 60MP Frontkamera Dual SIM a F NEUE SuperCharge für Google 199,259, 249,P B a Frontkamera F A 1 N F R A E N Keine Kosten oder Gebühren 0,0% eff.p.a, Laufzeit: 36 Monate*** 0% Finanzierung ab 100,hartlauer.at/finanzierung -18% AKTION STATT 159,95* NUR 129, , 95 9 STATT 249,95* NUR 229, , 95 STATT 549, * NUR 499,499 MATEPAD TABLET STARKE AKKULAUFZEIT • 10,4“ 2K HUAWEI Display • Multi Window Funktion • 4 fach Lautsprecher Soundsystem • 128GB interner Speicher • 7 250 mAh Akku • GSpace App: für alle Google Dienste wie Google Maps 13MP Backkamera 8MP Frontkamera
•































































VORTEILE Löwenstarke Ein Geschenk mit einfach MEHR Auswahl! Gutscheincards erhältlich im Geschäft & auf hartlauer at/gutscheincards FROHE WEIHNACHTEN h hartlauer.at Gut beraten bei FOTO, HANDY, OPTIK und HÖRGERÄTEN. MEIN HANDY-PROFI Seit Jahren: Weihnachtsfreude ganz nah. G11 OFFEN FÜR ALLE NETZE REIBUNGSLOSE LEISTUNG • 6,5“ Display 90Hz Bildfrequenz und 180Hz Touch Abtastrate • 32GB interner Speicher • Unisoc T606 • Android 11 13MP+2MP+2MP Triple Backkamera 8MP Frontkamera Dual SIM X30 OFFEN FÜR ALLE NETZE UMWELTFREUNDLICH, OHNE KOMPROMISSE • 6,43“ AMOLED Display • Qualcomm Snapdragon 695 5G • 128GB interner Speicher • Android 12 50MP+13MP Dual Backkamera 16MP Frontkamera Dual SIM 225 OFFEN FÜR ALLE NETZE KLASSISCH TRIFFT ZEITGEMÄSS • 2,4“ QVGA Display • Bluetooth 5 0 + 4G • 2 in 1 Lautsprecher • Unterstützt VoLTE 0,3MP Backkamera Dual SIM 2720 OFFEN FÜR ALLE NETZE EINFACH UND ZUVERLÄSSI • 2,8“ Display • 1500mAh Akku • 32GB ROM • Bluetooth 4 2 + 4G • Eingebaute Notfalltaste 2MP Backkamera Dual SIM 8210 OFFEN FÜR ALLE NETZE DIE WIEDERGEBURT EINES KLASSIKERS • 2,8“ QVGA Display • 128MB interner Speicher • Bluetooth 5 0 • Betriebssystem: S30+ 0,3MP Backkamer Dual SIM G60 OFFEN FÜR ALLE NETZE ERSTKLASSIGE LEISTUNG, NACHHALTIG HERGESTELL • 6,58“ Flat Display (120Hz • Qualcomm Snapdragon 695 5G • 4GB RAM/128GB ROM • Android 12 50MP+5MP+2MP Triple Backka 8MP Frontkam Dual SIM G21 OFFEN FÜR ALLE NETZE KLARES UND HELLES DISPLAY • 6,5“ HD+ Display • Prozessor Unisoc T606 • 64GB interner Speicher • Bluetooth 5.0 Dual SIM 50MP+2MP+2MP Hauptkamera 8MP Frontkamera ZUVERLÄSSIG 79,95 59, , 95 99,95 149,149, 179,179, 0,3MP Backkamera Backkamera Frontkamera HERGESTELLT (120Hz) STATT 349, * NUR 329,329 oder zu 36 Monatsraten á 9,69*** 519,oder zu 36 Monatsraten á 14,42*** Online und auch in allen Geschäften bestellbar












































































































VORTEILE Löwenstarke Hartlauer Smartphone Rückkaufbonus Mehr auf hartlauer at/smartphonerueckkauf 18 19 Individuelle Freude schenken! Mehr auf hartlauer.at/gutscheincards FROHE WEIHNACHTEN Die angegebenen Stattpreise beziehen sich auf die unverbindlichen Verkaufspreise des Herstellers Die beworbenen Produkte sind nicht in jedem Geschäft lagernd auf Bestellung erhältlich Abgabe der Ware erfolgt nur in Haushaltsmengen Gültig solange der Vorrat reicht Die Angabe der verfügbaren Speicherkapazitäten ist aufgrund der Mobiltelefon Software geringer Druck und Satzfehler vorbehalten Die dargestellten Preise sind per 30 11 gültig und können sich ändern Die tagesaktuellen gültigen Preise finden Sie in Ihrem Hartlauer Geschäft oder online unter www hartlauer at TOUCHSMART.2 OFFEN FÜR ALLE NETZE DAS INTELLIGENTESTE KLAPPTELEFON • Sprachassistent • Großes Display mit gut lesbarer Schrift Emporia Notruffunktion • IP54 Spritz wasserschutz 8MP Backkamera 2MP Frontkamera JOY OFFEN FÜR ALLE NETZ TOP SPRACHQUALITÄT • Einfache Bedienung • Zusätzlicher Akkudeck ohne Notruf Taste • Austauschbarer Akku • 3 Kurzwahltasten 2MP Hauptkamera NETZE Akkudeckel SUPEREASY OFFEN FÜR ALLE NETZE NOCH NIE WAR TELEFONIEREN EINFACHER • 5“ Display • NFC für kontaktloses Bezahlen • Inkl Trainingsbuch • LTE Mobilfunk Stand • Austauschbarer Akk 13MP Backkame 5MP Frontkame SMART.4 OFFEN FÜR ALLE NETZE HANDLICH UND KOMPAKT • 5“ Display • 1,5GHz Quad Core Prozessor • 32GB interner Speicher • Inkl Trainingsbuch • Inkl. Ladeschale 13MP Backkamera 5MP Frontkamera SMART.5 OFFEN FÜR ALLE NETZE SMART UND UNKOMPLIZIERT • emporia Notruffunktion • IP54 Spritzwasserschutz • Großes Display mit gut lesbarer Schrift • Google Assistant • Inkl Smartphone Ratgeber 13MP+2MP+2MP Triple Backkamera 8MP Frontkamera TABLET TABLET EINFACHE BEDIENUNG • Kamera 13/5 Megapixel • Ladeschale & Wandhalterung • WhatsApp • Tablet Ratgeber • Texteingabe durch Sprachansage • SIM Karte möglich 13MP Backkamera 5MP Frontkamera 169,69, , 95 99,95 129,GRATI im Wert von 99,95 GRATIS UV Desinfektio i Wert von Tastatur m W t v n SIMPLICITY OFFEN FÜR ALLE NETZE IMMER GUT ERREICHBAR • Notruffunktion • Spritzwasserschutz • Einfache Bedienung • Speicher 32MB/64MB Standard Akku P B a P F m W t v n 14,95 249,249 oder zu 36 Monatsraten á 6,92*** 229,229 Statt einzeln 234,95* im Set nur 299,95 Statt einzeln 399,90* -24% im Set nur

























































































































SERVICES Löwenstarke Einfach MEHR Ersteinrichtungsservices für Smartphones, Tablets & Co hartlauer at/smartstart uzsiBExklusivfür LöwenclubMitglieder BISZU-10% ** hartlauer.at Gut beraten bei FOTO, HANDY, OPTIK und HÖRGERÄTEN. MEIN HANDY-PROFI Seit Jahren: Weihnachtsfreude ganz nah. Bei Einlösung von 10 000 Leos Mehr auf hartlauer at/loewenclub ***Details zur Santander 0% Finanzierung auf Seite 12 SL645 PLUS OFFEN FÜR ALLE NETZE STAUB UND SPRITZWASSERFEST • Extra Groß und extra schmal • Annahme/Beenden Taste am Außendisplay • Einfache Bedienung • SOS Notruftaste • Inkl. Tischladestation 3MP Kamera 79,95 C245 OFFEN FÜR ALLE NETZE HANDLICHES KLAPPHANDY • 2,4“ (6,1cm) Farbdisplay • Kamera für Schnappschüsse • FM Radio, Kalender, Wecker, Taschenrechner 49,95 0,3MP Kamera Dual SIM 13MP Backkamera 5MP Frontkamera M7 LITE PREMIUM OFFEN FÜR ALLE NETZE EINFACH UND SICHER • Beafon be easy und Android • HAC M4/T4 Hörgeräte kompatibel • Home Button + Fingerprint • SOS Notruftaste • 5,5“ Display • WhatsApp vorinstalliert 199,13MP Backkamera 5MP Frontkamera M7 PREMIUM OFFEN FÜR ALLE NETZE KABELLOS LADEN • Beafon be easy und Android • HAC M4/T4 Hörgeräte kompatibel • Home Button + Fingerprint
SOS Notruftaste • 5,5“ Display
WhatsApp vorinstalliert 229,SL590 OFFEN FÜR ALLE NETZE KLAPPHANDY MIT AUSSENDISPLAY • Einfache Bedienung • S O S Notruftaste • 2,4“ TFT (6,1cm) Farbdisplay • Große beleuchtete Tasten • Extra lauter Klingelton • Inkl Tischladestation 3MP Kamera -23% AKTION STATT 64,95, * NUR 49,95 • Einfach zu bedienen • SOS Notruffunktionen • be easy oder Android Desktop • Große Kacheln und große Schrift • Quick Support (Remote Funktion) • Wetteranzeige inkl. 1 Wochen-Vorschau TL20 32GB TABLET FÜR UNTERWEGS • 4G (LTE) • Be easy oder Androi • 10,1“ Display • SOS Notru funktion (G • MikroSDSlot bis128GB Android Notruf (GPS) 8MP Backkamera 5MP Frontkamera GRATIS Fel Tablethalter im Wert von 19,95 Feli Fron Inkl hochwertigem Book Cover TW10 TABLET FÜR WLAN • Be easy oder Andr • 10,1“ Disp • Skype App • Freisprech einrichtun Android Display einrichtung 5MP Backkamera 2MP Frontkamera GRATIS Fel Tablethalter im Wert von 19,95 Feli 229,95 Statt einzeln 249,90* im Set nur 179, , 95 Statt einzeln 199,90* im Set nur
•
•
•
• Herzfrequenzmessung und Pulse Ox Sensor am Handgelenk, für den perfekten Einblick in Ihre Fitnessaktivitäten





• Dynamische PacePro Funktion für die bessere Einteilung Ihrer Kräfte in verschiedenen Terrains




















































•

UNSCHLAGBAR

UNSCHLAGB VIELSEITIG



• Bis zu 37 T
Akkulaufzeit mit Solarladun Smartwatc

• Vorinstallie Europa Kar

• 1,4“ Touchs







zu Tage Solarladung im Smartwatch Modus Vorinstallierte Karte Touchscreen






• Integrierte Taschenlampe

SMARTWATCH
FENIX 7X SOLAR
20 21 Stattpreiserklärung siehe S 02 03 Details zur Santander 0% Finanzierung auf Seite 12 ***Bei Einlösung von 10 000 Leos Mehr auf hartlauer at/loewenclub Die Samsung Cashback Aktion gilt für alle teilnehmenden Produkte von 29 11 2022 bis 15 01 2022 in allen Hartlauer Geschäften und im Hartlauer Onlineshop Der Kauf muss im Aktionszeitraum unter cashback samsung at registriert werden Nach erfolgreicher Prüfung wird Ihnen der vom Produkt abhängige Cashback Betrag direkt von Samsung auf Ihr Konto überwiesen Details auf hartlauer at/samsungcashback Bis zu -10% Leos-Sofortrabatt Mehr auf hartlauer.at/loewenclub Smartwatch für Profis Smartwatch für Profis FENIX 6 SAPPHIRE SMARTWATCH
GEHT MIT IHNEN DURCH JEDES ABENTEUER
Vorinstallierte Skikarten für 2 000 weltweite Skiorte
und
339,159, 59,95 -15% -41% VENU 2S SMARTWATCH DIE NEUE SMARTWATCH GENERATION
Umfangreiche Funktionen zur
AMOLED Display VENU 2 PLUS SMARTWATCH DEN NEUEN KOMFO GENIESSEN
GPS
Innovative Messverfahren für Ihre Lauf
Radfahrleistung
•
Gesundheits analyse • Über 25 vor installierte Sport Apps • Lassen Sie sich von Ihrer Lieblingsmusik begleiten • Brillantes
•
Fitness Smartwatch mit 1,3“ AMOLED Touchdisplay
FORERUNNER 55 SMARTWATCH SCHRITT FÜR SCHRI IHRE ZIELE ERREICH
Fitness Tracking
Body Battery Energylevel
Anzeige Ihrer Atemfrequenz
Menstruations zyklus Tracker
Sicherheits und Tracking Funktionen Smartwatch für Fortgeschrittene VIVOACTIVE 4S SMARTWATCH
BEHALTEN PS Fitness martwatch m ocheffiziente IP Display ößte
Fitn Tracking
2
und Pilates DIE mit
Vielfalt
SCHRITT ERREICHEN KOMFORT 249,249, Version 40mm 299,VENU SQ 2 MUSIC SMARTWATCH LERNEN SIE IHREN KÖRPER NOCH BESSER KENNEN • GPS Fitness Smartwatch m 1,4“ AMOLED Display • Über 25 vor installierte Sport Apps • Akkulaufzeit v bis zu 11 Tagen • Ganztägige Gesundheitsan l • Smart Notifica Smartwatch für Fortgeschritte oga • • • • mit von 11 Gesundheitsanalyse Notifications Fortgeschrittene Smartwatch für Fortgeschrittene Smartwatch für Fortgeschrittene Smartwatch für Fortgeschrittene N I C O U N S E R M E H R A N W I S S E N : „ Die Garmin Fenix 6 Sapphire begleitet Sie durch jedes Abenteuer und hebt Ihr Training auf ein neues Level Ausgestattet mit Karten, Musik, Pace Überwachung und mehr, erreichen Sie mit dieser GPS Multisport Smartwatch Ihre persönlichen Ziele AKTION STATT 449,95* NUR 379,AKTION STATT 949, * NUR 555,789,oder zu 36 Monatsraten á 21,92**
• Telefonie und Sprachassistenz kompatibel via Bluetooth
•
•
•
•
•
DIE GESUNDHEIT IM AUGE
Vielfal ealth &
Funk ber 40 Traini g nimierten Üb m Nachmac Über 20 Sport klusive dem neuen oga
0
ocheffizientem
an ealth- Fitness Funktionen Trainings mit Übungen m Nachmachen Apps,





















































uzsiBExklusivfür Löwenclub-Mitglieder BISZU-10% *** hartlauer.at Gut beraten bei FOTO, HANDY, OPTIK und HÖRGERÄTEN. Seit Jahren: Weihnachtsfreude ganz nah. MEIN HANDY PROFI Smartwatch für Profis SMARTWATCH WEIL JEDER SCHRITT ZÄHLT • Aluminium & Sapphire Crystal Glas • Puls, EKG, BP, BIA, dauerhafter SpO2 • Fitnesslevel und Gesundheitsdaten Tracking • Staub , wasser und fallresistent (5ATM + IP68) Smartwatch für Profis Smartwatch für Profis SMARTWATCH ZEIT FÜR GROSSE LEISTUNG • Aluminium & Sapphire Crystal Glas • Schlaftracker misst & analysiert 4 Schlafphasen • Sturzerkennung mit SOS Notruf Funktion • Smartphone Kamera Auslöser SMARTWATCH GESUNDHEIT TRÄGT MAN JETZT • Titan & Sapphire Crystal Glas • Personalisierter Fitness Coach mit Trainingsprogrammen • Import von Workout Routen im GPX Format • BIA (Analyse der Körper zusammensetzung: u a Muskelmasse, Körperwasser, u v m ) 299, , 95 Version 40mm 329,95 Version 44mm 429,, Jetzt Cashback holen! Bildsimuliert Aktiongültigbis3112 2022 DieHöhedesCashbackBetragesistabhängigvomgekauftenModell AlleDetailsunterhartlauerat/samsungcashback Bis zu 60€ Cashback*** beim Kauf eines Galaxy Watch5 Serie Modells abzgl. 40,- Cashback 259,95**** abzgl. 40, Cashback 289,95**** abzgl. 60, Cashback 369, ****
PARTY SPEAKER 80W




LAUTSPRECHER










ERLEUCHTET JEDE PARTY



• Bluetooth 5 0




























• Tragbar mit wieder aufladbarem Akku
• Laufzeit bis zu 14h

• TWS Funktion: Koppelbar mi anderen Speakern

• 8“+8“ Lautsprecher, Leistung: 80W
FÜR UNTERWEGS
• Kapazität: 30 000mAh




• Leistung: 65W

• Gewicht: 610g
• Für das schnelle Aufladen Ihres Laptops oder MacBooks

• Auch für Smar geeignet Smartp

POWERBANK 130W POWERBANK












POWER TO GO
• Kapazität: 20 000mAh


• Leistung: 130W


• Gewicht: 426g


• Für das schnelle Aufladen Ihres Laptops oder MacBooks

• Auch für Smartphones geeignet

OVER EAR KOPFHÖRER
EIN EINZIGARTIGES SOUNDERLEBNIS

• Aktive Geräuschunterdrückung (bis zu 25dB)
• Intelligente Wiedergabe: automatischer Start/Stopp der Musikwiedergabe durch Aufsetzen/Abnehmen des Kopfhörers

• Hohe Klangqualität
• Perfekter Tragekomfort
LADER PD USB C MINI LADEGERÄT
POWER TO GO
• Kompaktes Design
• Eingang: AC 100 2
• Gesamtleistung: 3
240V 30 Watt C Ausgang: 3A/12V

• USB C (PD) Ausga DC 5V 3A/9V 3A/1 2 5A/15V 2A/20V 1 5A (30W)
Ein Geschenk mit einfach MEHR Auswahl! Gutscheincards erhältlich im Geschäft & auf hartlauer at/gutscheincards
VORTEILE Löwenstarke
FROHE WEIHNACHTEN
22 23 Stattpreiserklärung siehe S 02 03
Freude
Mehr auf hartlauer.at/gutscheincards FROHE WEIHNACHTEN BUDS TRUE WIRELESS KOPFHÖRER S T E BLUETOOTH
Individuelle
schenken!
INEAR-KOPFHÖRER KOPFHÖRER
REINIGUNGSSET FÜ RE R K REINIGUNGSSET BLUETOOTH IN EAR
KOPFHÖRER
KOPFHÖRER
BLUETOOTH
mit
POWERBANK 65W POWERBANK SCHLANKES DESIGN
99, , 95 9,95 99,95 27, -24% -60% -58% -50% -27% NEU
AKTION STATT 99,-* NUR 39,39 AKTION STATT 39,95* NUR 29,, AKTION STATT 99,95* NUR 49, , 97 AKTION STATT 59,95* NUR 25,25 AKTION STATT 199,-* NUR 150,-
20V/3,25A;




























































































•

VORTEILE Löwenstarke Zusätzlich beim Kauf eines Smartphones –15% auf Zubehör sparen! hartlauer.at Gut beraten bei FOTO, HANDY, OPTIK und HÖRGERÄTEN. MEIN HANDY-PROFI Seit Jahren: Weihnachtsfreude ganz nah. 19,95 29, , 95 54,95 -57% -33% -63% AERO PRO KOPFHÖRER IDEAL FÜR SPORT
Hält perfekt im Ohr
6x Laden = 30h Super Sound
Ladebox 1000mAh auch Notfall Powerbank
Hygiene durch UV C Licht PREMIUM PD NYLON USB C FAST CHARGE LADEKABEL FLOTT UND ZUVERLÄSSIG PREMIUM PD MFI USB C LIGHTNING FASTCHARGE LADEKABEL SCHNELLE ÜBERTRAGUNGSRATE PREMIUM REISELADER LADEGERÄT DIE „WAFFE“ LADER DER SPITZENKLASSE
Lädt Smartphones, Tablets und Notebooks mit USB C
65W (max.)
USB
PPS:
11V/5A INFLUENCER GREEN/BLUESCREEN INFLUENCER 10” RGB RING LIGHT INFLUENCER STATIV INKL. PHONE HOLDER STATIV FAMILY POWERBANK „PHANTOM II 30“ POWERBANK GENUG ENERGIE FÜR ABENTEUERLICHEN T • Bis 5 Geräte gleichzeitig laden • 4x USB A/ 1x USB Typ C • Genug Energie für al (30 000mAh)! AERO 3 KOPFHÖRER UNVERGLEICHLICHER MUSIKGENUSS
32 Ohm
Laufzeit mit 1 Aufladen:
zu 6h
Kleines, ovales Etui INFLUENCER 360° TRACKING GIMBAL 12,, 49, , 95 49, 5 29, , 95 • Hält • 6x = • –• AKTION STATT 69,-* NUR 29,29 AKTION STATT 59,95* NUR 39,95 AKTION STATT 79,95* NUR 29,, EINEN TAG alle
•
•
•
•
•
• Ausgänge:
Typ C: 5V/3A, 9V/3A, 12V/3A, 15V/3A,
3,6V
• Atemberaubende Soundqualität • Lautsprecher 14mm,
•
bis
•
ROOMBA i7+ STAUBSAUGROBOTER MIT ABSAUGSTATION


LASSEN SIE DIE









RÄUME REINIGEN

• 3 Stufen Reinigungssystem
• Individuelle Reinigung per App
• Sprachassistent kompatibel
• Inkl automatischer Absaugstation

SAFER 1S
OUTDOOR KAMERA
MEHR SICHERHEIT
• Weitwinkel 130°
• 100% kabellos (Plug&Play)
• Schutz gegen Wasser und Staub (IP 65)
• Infrarot Nachtsensor (bis zu 10m)
• Intelligente Bewegungserkennung
• LED Licht
• Leuchtstärke: 850lm
• Leuchtweite: bis zu 200m
• Leuchtdauer: bis zu 6h
• Ladezeit: ca 4h


•

SAFER 2S PRO OUTDOOR KAMERA

BRAAVA JET M6 WISCHROBOTER
ULTIMATIVER WISCHROBOTER MIT PRÄZISIONS SPRÜHSTRAHL


• Verbesserte Form für saubere Ecken und Kanten
• Nasswischtücher













• Trockenwischtücher




• Intelligente Navigation
IHR ZUHAUSE IMMER IM BLICK
• 100% kabellos
• Akku 9600mAh (Standby bis zu 6 Monate)

• IP65 Schutz gegen Staub und Strahlwasser

• Kamera zum Schwenken und Neigen
• Tag und Nachtmodus/ Infrarot Nachtsensor
• Intelligente Bewegungserkennung
•



• Leuchtstärke: 1500lm

• Leuchtweite: bis zu 250m

• Leuchtdauer: bis zu 8h
• Ladedauer: ca 6h
•

5W - USB TYP-C SOLAR PANEL
POWER DIREKT
VON DER SONNE
• Max Leistun 5W
• Toleranz: +/
• IP65 geschüt
• 3m Kabelläng
Max. Leistung: +/- 5 geschütz Kabellänge
LEISTUNGSSTARK UND KOMPAKT ZUGLEICH
• LED Licht
• 4 Lichtmodi: Niedrig Mittel Hoch Blitzlicht
• Leuchtstärke: 2600lm
• Leuchtweite: bis zu 320m
• Leuchtdauer: bis zu 7,5h
• Zoomfunktion & Campinglicht
oder
Geschäft
Nicht in allen Geschäften lagernd Auf Bestellung erhältlich 99,95 Nicht in allen Geschäften lagernd Auf Bestellung erhältlich 149, Nicht in allen Geschäften lagernd Auf Bestellung erhältlich 59, , 95 729,, oder zu 36 Monatsraten á 20,25** 24 25 Stattpreiserklärung siehe S 02 03 **Details zur Santander 0% Finanzierung auf Seite 12 Bei Verwendung der beworbenen Medizinprodukte ist die Gebrauchsanweisung genau zu beachten und erforderlichenfalls der Rat eines Arztes Zahnarztes Apothekers oder einer sonstigen aufgrund ihrer beruflichen Ausbildung dazu befugten Person einzuholen Bis zu -10% Leos-Sofortrabatt Mehr auf hartlauer.at/loewenclub
Erhältlich im Hartlauer Plus Sortiment: jetzt auf hartlauer at oder im Geschäft bestellen! Erhältlich im Hartlauer Plus Sortiment: jetzt auf hartlauer at
im
bestellen!
49,95 39, , 95 59, , 95
-28% AKTION STATT 699, * NUR 499,Keine Kosten oder Gebühren 0,0% eff.p.a, Laufzeit: 36 Monate** 0% Finanzierung ab 100,hartlauer.at/finanzierung Auchim Onlineshop ! CLASSY TASCHENLAMPE STYLISCH UND SUPERHELL
ADVENTURE TASCHENLAMPE ERHELLT MÜHELOS DIE STRASSE
• Als Powerbank verwendbar
LED
Licht
Mittel
5 Lichtmodi: Niedrig
Hoch Blitzlicht SOS
Als Powerbank verwendbar EXPLORE TASCHENLAMPE
BU 512
OBERARM BLUTDRUCKMESSGERÄT
LEICHTE LESBARKEIT
• Je 90 Speicherplätze für 2 Benutzer
• Arrhythmie Erkennung
• Einstufung der Messwerte durch WHO Ampel Farbskala
• Berechnung des Durchschnittswerts aller gespeicherten Werte
• Oberarmmanschette für 22 36cm Armumfang
• Inkl Batterien (4x1,5V AA)




















HD 150X XL NORDIC WÄRMEZUDECKE
FLAUSCHIG WEICH UND TRAUMHAFT KUSCHELIG



• Luxuriöses Obermaterial

• 6 beleuchtete Temperaturstufen

• Elektronische Temperaturregelung





• Maße: 200x150cm







• Abschaltautomatik nach ca 3h
BM 81


OBERARM BLUTDRUCKMESSGERÄT

BLUTDRUCKMESSEN SO EINFACH WIE NOCH NIE
• Mit innovativer Manschette ohne Schläuche oder Kabel

• Sanfter Druckaufbau & schnelle Messzeit

• Medizinprodukt mit App Anbindung
• Arrhythmie Erkennung
FB 30
FUSSBAD


LÄSST SICH GANZ EINFACH



ZUSAMMENFALTEN











• 3 Funktionen: Vibrationsmassage, Sprudelmassage, Wassertemperierung

• Wohltuende Infrarot Lichtpunkte
• Mit Pediküreaufsatz (Bimsstein)
• Massageunterstütztes Fußbett
hartlauer.at Gut beraten bei FOTO, HANDY, OPTIK und
Seit
Weihnachtsfreude ganz nah. hartlauer.at GESUNDHEIT
HÖRGERÄTEN.
Jahren:
29,95 *** -29% -23% -14% AKTION STATT 69,95* NUR 49,AKTION STATT 129, * NUR 99,VORTEILE Löwenstarke Viele weitere Produkte, um fit und gesund zu bleiben auf hartlauer.at/gesundheit Leos einlösen lohnt sich! Jetzt rechtzeitig bis zum 31.12.2022 Punkte einlösen und bis zu -10% auf Ihren gesamten Weihnachtseinkauf sparen nutzen Sie die Gelegenheit
aktuellen Punktestand finden Sie auf Ihrer letzten Hartlauer Rechnung und in Ihrem Online Konto auf hartlauer.at Mehr Infos auf hartlauer.at/loewenclub BISZU LEOS-SOFORTRABATT bis31.12.2022einlösen -10% AKTION STATT 139,95* NUR 119,, ***
Ihren
•
• 10,1“ (25,6cm) Displ
























































• Helio P22T



•


MATEPAD T10S


TABLET
DAS TABLET FÜR ALLES


• 10,1“ FHD IPS Display

• Augenkomfort Modus

• Dual Lautsprecher System
•
•
TABLET
SO ELEGANT KANN ENTERTAINMENT SEIN
• 10 5“ WUXGA PLS TFT Display (1 920x1 200)
• Octa Core Prozessor
• 32GB interner Speicher
• 7 040mAh mit 15W Schnellladen
• Großartiges Seherlebnis, imposante Klangkulisse mit Surround Sound aus 4 Lautsprechern und jede Menge Power
8MP Backkamera 5MP Frontkamera
• 10,3“ (26,2cm) Display
• Helio P22T
ENVY 6010E AIO
• Drucken, Kopieren, Scannen
• Druckgeschwindigkeit bis zu 10 Seiten/Min (Schwarzweiß) und 7 Seiten/Min (Farbe)
• Bis zu 1200x1200 dpi gerendert (beim Drucken über einen Computer)
• Drucken, Kopieren, Scannen
• Druckgeschwindigkeit bis zu 7,7 Seiten/Min (Schwarzweiß) und 4 Seiten/Min (Farbe)
• Bis zu 4 800x1200dpi gerendert (beim Drucken über einen Computer)
• Kompatibel mit Mobilgeräten
36
** 0% Finanzierung ab 100,hartlauer.at/finanzierung Auchim Onlineshop ! 26 27 Stattpreiserklärung siehe S 02 03 **Details zur Santander 0% Finanzierung auf Seite 12 Intel das Intel Logo das Intel Inside“ Logo und Intel Core sind Marken der Intel Corporation oder ihrer Tochtergesellschaften HP+ erfordert einen HP Account eine Internetverbindung und die Entscheidung zur ausschließlichen Nutzung von Original HP Tinte oder Toner während der Lebensdauer des Druckers Alle Details auf hp com/plus Individuelle Freude schenken! Mehr auf hartlauer.at/gutscheincards FROHE WEIHNACHTEN TAB
TABLET
Keine Kosten oder Gebühren 0,0% eff.p.a, Laufzeit:
Monate
M10 2ND GEN
DOLBY ATMOS® FÜR KOMPROMISSLOSEN
4GB RAM/64GB RO
5.000mAh AB M10 PLUS 64GB ABLET SETZT NEUE MASSSTÄBE FÜR TABLETS
5MP
B
P Ba F 159,95
• 4GB RAM/64GB ROM 8MP Backkame
Frontkamera 8MP Backkamera 5MP Frontkamera
M 0 6 K 10,1“ Displ
8
5 100mAh Akku 5MP Backk 2MP Front a B M 0 P US 6 TABLET
P
• • TABLET FHD
B a F
ALL IN ONE DRUCKER
EINFACH ZU BEDIENEN
TS3450 PIXMA INKJET ALL IN ONE DRUCKER GANZ EINFACH
INTELLIGENT
HP+ wählen und Vorteile sichern -11% -12% -12% 199,95 64GB AKTION STATT 179,95* NUR 159, , 95 AKTION STATT 249,95* NUR 219,95 9 AKTION STATT 79, * NUR 69,69 STATT 109, * NUR 99,, oder zu 36 Monatsraten á 6,11**




























































SERVICES Löwenstarke Ladebons vieler Marken und Hersteller & Hartlauer Gutscheincards im Hartlauer Geschäft erhältlich: hartlauer at/geschaeftefinder hartlauer.at Gut beraten bei FOTO, HANDY, OPTIK und HÖRGERÄTEN. Der Zeitpunkt des Upgrades kann je nach Gerät variieren Features und App Verfügbarkeit können je nach Region variieren Bestimmte Features erfordern spezielle Hardware (siehe aka ms/windows11 spezifikationen ) MEIN HANDY-PROFI Seit Jahren: Weihnachtsfreude ganz nah. 14S FQ1804NG NOTEBOOK GENÜGEND LEISTUNG ÜBERALL • AMD Ryzen™ 3 5300U Prozessor (bis zu 3,8GHz max Boost Taktung, 4MB L3 Cache,4 Kerne, 8 Threads) • 14“ Full HD Display • AMD Radeon™ Grafikeinheit • Windows 11 15S FQ2807NG NOTEBOOK ZUVERLÄSSIGE LEISTUNG FÜR DEN ALLTAG • Intel® Core™ i3 1125G4 Prozessor • 15,6“ Full HD Display • 8GB DDR4 RAM • Windows 11 13 AY0455NG NOTEBOOK KREATIVITÄT OHNE GRENZEN • AMD Ryzen™ 5 4500U Prozessor • 13,3“ FHD Display • 8GB DDR4 3200 • AMD Radeon™ Grafikeinheit • Windows 11 Home • 512GB SSD interner Speicher -18% -16% -16% FOTO HANDY HÖRGERÄTEN kann variieren. können Region *Einlösbar im PlayStation™Store PS Plus ist ein laufendes Abonnement mit wiederkehrenden Abonnementgebühren, die automatisch in der beim Kauf gewählten Frequenz abgebucht werden, bis das Abonnement gekündigt ist Es gelten die Nutzungsbedingungen: play st/psplus usageterms © 2022 Sony Interactive Entertainment LLC All rights reserved PlayStation P ayStat on Family Mark Play Has No Lim ts are registered trademarks or trademarks of Sony Interactive Entertainment Inc SPIELE,ADD-ONS,PLAYSTATION®PLUSUNDMEHR PLAYSTATION GESCHENK DAS PERFEKTE Mit Touch-Display AKTION STATT 899, * NUR 749,AKTION STATT 599, * NUR 499,, AKTION STATT 529, * NUR 429,-
•
•
•
•
•
NOCH MEHR VON IHRER WELT EINFANGEN
•
• Augen Autofokus























• 4K (30P)/Full HD (120P)











































• Richtmikrofon mit Windschutz



mit 24,5MP • Außergewöhnlich großer
• Zwei Speicherkartenfächer • Augen AF für Menschen, Hunde und Katzen • Schutz vor Staub, Schmutz und Feuchtigkeit
• Doppelbelichtung
• Selfie Spiegel und Selbstauslöser
• Eingebauter Blitz
28 29 ****Die Sony Cashback Aktion gilt für alle teilne 1 2022 bis zum 15 01 2023 in allen Hartlauer Geschäften und im Hartlauer Onlineshop Der Kauf muss im Aktionszeitraum unter www sony at/cashback/ winter registriert w üfung wird Ihnen der vom Produkt abhängige Cashback Betrag direkt von Sony auf Ihr Konto überwiesen Details auf hartlauer at/sony wintercashback *****Die Canon Cashback Aktion gilt für a vom 24 10 2022 bis zum 31 12 2022 in allen Hartlauer Geschäften und im Hartlauer Onlineshop Der Kauf muss im Aktionszeitraum unter www canon at/ winter cashback registriert werden Nach erfolgreicher Prüfung wird Ihnen der vom Produkt abhängige Cashback Betrag direkt von Canon auf Ihr Konto überwiesen Details auf hartlauer at/canon wintercashback Bis zu -10% Leos-Sofortrabatt Mehr auf hartlauer.at/loewenclub uzsiBExklusivfür Löwenclub Mitglieder IS 10% *** POWERSHOT ZOOM DIGITALES MONOKULAR MIT FOTO /VIDEOFUNKTION UNGLAUBLICHER ZOOM • 3 Stufen Brennweite: 100mm/400mm optisch, 800mm digital • 12,1MP Fotos • Full HD Videos % % % % % % % % % % % % % % % % % % %AKTION Brüller hartlauer.at/foto-aktionswochen 289,289, abzgl. 50, Cashback 239, BISU-10% Z 6II + Z 24 70MM/4,0 S SYSTEMKAMERA SET SETZEN SIE IHRE IDEEN INS BILD
Nicht in allen Geschäften lagernd 2.349,Statt 2.749, * 400, Sofortrabatt nur Cashback Aktion teilnehmenden Produkte vom 01 11 zum werden. Nach erfolgreicher Prüfung Cashback überwiesen. Aktion alle teilnehmenden Produkte zum muss GO EVERYTHING BOX SOFORTBILDKAMERA SET SO VIELE ORTE WARTEN
SIE
• Vollformatsensor
ISO Spielraum
AUF
Analoge Sofortbildkamera im Taschenformat
129, , 95 Doppelpackung 2x8 Aufnahmen inkludiert g ALPHA 7 II + OBJEKTIV 28 70MM/3,5 5,6 OSS SYSTEMKAMERA SET GRENZENLOSE
STABILITÄT
Voll formatsensor mit 24,3 MP
• EXMOR CMOS
Leistungsstarker und schneller Hybrid Autofokus
5 Achsen Bildstabilisierung
Full HD Videoaufnahmen
5,6 OSS SYSTEMKAMERA
ALPHA ZV E10 + OBJEKTIV SEL 16 50MM/3,5
SET
24,3MP APS C Sensor
Schnelle und intuitive Vlogging Bedienung
2+1 GRATIS Für ungetrübte Weihnachtsfreude: Batterien nicht vergessen! Gültig auf alle lagernden Varta Batterien Nicht in allen Geschäften lagernd Nicht in allen Geschäften lagernd 789,789, 999,999oder zu 36 Monatsraten á 27,75**
• EXMOR R CMOS Voll formatsensor mit 24,3MP




































• Fantastische Autofokusleistung und Serienaufnahmen mit 10 Bildern/s


• Vollformatige 4K HDR Video aufnahmen und Profi Videofunktionen
• AF mit Augenerkennung
• OLED Tru Finder mit hoher Auflösung
• 7,6cm
OLED Sucher mit 5 76 Mio Bildpunkten
• EXMOR R CMOS
Vollformatsensor mit 24,3MP
• Erweiterte AF Leistung und Funktionen
• Hochauflösende 4K Videos
• Benutzerfreundlichkeit und Zuverlässigkeit
VORTEILE Löwenstarke Hartlauer Kamera- und Objektiv Rückkauf Mehr auf hartlauer at/kamerarueckkauf hartlauer.at Gut beraten bei FOTO, HANDY, OPTIK und HÖRGERÄTEN. hartlauer.at FOTO Seit Jahren: Weihnachtsfreude ganz nah. *Stattpreiserklärung siehe S 02 03 Details zur Santander 0% Finanzierung auf Seite 12 Bei Einlösung von 10 000 Leos Mehr auf hartlauer at/loewenclub Entscheidende Momente n CASHBACK 200€ CASHBACK 50€ CASHBACK 100€ CASHBACK 100€ CASHBACK 100€ CASHBACK 100€ 769,7 abzgl 100, Cashback 669, Nicht in allen Geschäften lagernd CK € 1.059,abzgl 100, Cashback 959, Nicht in allen Geschäften lagernd 729,72 abzgl 100, Cashback 629, Nicht in allen Geschäften lagernd 899,abzgl 100, Cashback 799, Nicht in allen Geschäften lagernd 539,39,abzgl 50, Cashback 489, Nicht in allen Geschäften lagernd 999,abzgl 200, Cashback 799, Nicht in allen Geschäften lagernd Sony Cashback vom 01.11.2022-15.01.2023 SEL 11MM/1,8 ULTRAWEITWINKELOBJEKTIV SEL FE 70-300MM/4,5-5,6G OSS TELEOBJEKTIV SEL 55MM/1,8 ZA PORTRAITOBJEKTIV SEL 90MM/2,8G OSS MAKROOBJEKTIV SEL FE 24-105MM/4,0 G OSS ALLROUNDOBJEKTIV SEL 24-240MM/3,5-6,3 OSS REISEOBJEKTIV ALPHA 7R IVA GEHÄUSE SYSTEMKAMERA EIN WEITERER MEILENSTEIN • EXMOR R CMOS Voll formatsensor mit 61MP • Bessere Fotos mit dem AF mit Augenerkennung für Tiere • Großer Standard ISO Bereich (100 32000) • Hochauflösender
CASHBACK 300€ ** CASHBACK 200€ ** ALPHA 7C + OBJEKTIV FE 28 60MM/4 5,6 SYSTEMKAMERA SET AUSSERGEWÖHNLICHE
BILDQUALITÄT
Ausschließlich im Geschäft Hartlauer Haus Steyr erhältlich abzgl 300, Cashback 3 399, CASHBACK 200€ ** ALPHA 7 III + OBJEKTIV SEL 28 70MM/3,5 5,6 OSS SYSTEMKAMERA SET
HOHE LEISTUNG UND FLEXIBLE FUNKTIONEN
und hohem Kontrast
Touchscreen Nicht in allen Geschäften lagernd abzgl. 200,- Cashback 1.749,CK CK € € SONY ALPHA 7 III Gehäuse abzgl 200, Cashback um 1.599, Sony Alpha 7C Gehäuse 1 999, abzgl 200, Cashback um 1 799, 1.949,, 3.699,Nicht in allen Geschäften lagernd abzgl 200, Cashback 1 849, 2.049,2.049, ** ** **
LCD
•
•
• 1/1,3“
•
•
• Max Videoauflösung: 4k mit 30fps




































































•
• Kamera Sensor: 1/2,3 CMOS

• Max Flugzeit: 31min
•


•
•
• Objektivdurch messer: 42mm
• Vergrößerung: 8x
-11% AKTION Brüller 30 31 Stattpreiserklärung siehe S 02 03 Bei Einlösung von 10 000 Leos Mehr auf hartlauer at/loewenclub Details zur Santander 0% Finanzierung auf Seite 12 Individuelle Freude schenken! Mehr auf hartlauer.at/gutscheincards FROHE WEIHNACHTEN 2.6C REVIERKAME IDEAL FÜR ÜBERWACHUN • Fotoauflösu • 1080P FHD V • 2 0“ TFT Farbdisplay • Auslösezeit einer Sekun • 40 eingebau IR LEDs 99,95 149,95
DROHNE EINFACHSTE FLUGSTEUERUNG • 1 080P WiFi Kamera • Steuerung über App & Fernbedie • Flugzeit:
15m • Reichweit
300 • Foto & Video mittels Gestenerk Fly More Combo enthält: 1x Fluggerät 1x Fernsteuerung 3x Intelligent Flight Battery 3x Ersatzpropeller (Paar) 1x USB C Kabel 1x Gimbal Schutz 1x RC Kabel (Micro USB) 1x RC Kabel (USB C) 1x RC Kabel (Lightning) und vieles mehr Fly More Zubehör Kit bei gleichzeitigem Drohenkauf statt 189,95 15% nur 161,46 Fly More Zubehör Kit enthällt: 2x Intelligent Flight Battery 1x Zwei Wege Ladestation 1x Datenkabel 1x Umhängetasche 1x Erzatzpropeller & Schrauben MINI 3 PRO MIT DJI RC CONTROLLER DROHNE MINI IN DER GRÖSSE, MEGA BEI DEN FÄHIGKEITEN
MAKYA
bis zu
bis zu
Leistungsstark
wie handlich
Gewicht von weniger als 249g
Sensor
4K HDR Videos und 48MP RAW Fotos
SCOUT 8x42 FERNGLAS DER PERFEKTE BEGLEITER FÜR IHRE ABENTEUER
Sichtsensoren (vorne/hinten/unten)
• Wasserdicht
Stoßfest
Druckfest
Vor Beschlag geschützt
REVIERKAMERA ÜBERWACHUNG Fotoauflösung 12MP Video TFT unter Sekunde eingebaute -15% auf Zubehör bei Kamerakauf 559,559 Drohne ohne Fly More Combo 444, MINI 2 FLY MORE COMBO DROHNE EINZIGARTIGE PERSPEKTIVEN
Max. Foto auflösung: 12MP
über & Fernbedienung zu
Gestenerkennung -15% bei Drohnenkauf auf die Landeplattform im Wert von 14,95 AKTION STATT 179,95* NUR 159, 59,95 Nicht in allen Geschäften lagernd Nicht in allen Geschäften lagernd uzsiBExklusivfür Löwenclub-Mitglieder BISZU-10% ** 969,oder zu 36 Monatsraten á 26,91***
15min Reichweite: zu 300m







































































































































































otogeschenke Mitnehmen Fotocollagen & Fotostreifen Poster & Sofortfotos in vielen Formaten Bis 20x30cm Fotoalben Digitaler Bilderrahmen Direkt vom Smartphone ausdrucken & mitnehmen Wir digitalisieren Ihre alten Bilder, Dias und Negative für einfach MEHR Möglichkeiten Digitalisierung erfolgt direkt im Geschäft Wir sichern Ihre Bilder auf Wunsch auf USB-Stick, Speicherkarte oder CD/DVD Bringen Sie Ihre Lieblingserinnerungen vorbei und überzeugen Sie sich Mehr auf hartlauer.at/digitalisierungsservice s f Bilderrahmen In nur wenigen Minuten, in jedem Hartlauer Geschäft hartlauer.at Gut beraten bei FOTO, HANDY, OPTIK und HÖRGERÄTEN. Seit Jahren: Weihnachtsfreude ganz nah. 10,1“ Diagonale Auch Last Minute am 24.12. möglich!
Bis 18.12. bestellen & rechtzeitig











































































































































vor Weihnachten erhalten!

hartlauer.at Gut beraten bei FOTO, HANDY, OPTIK und HÖRGERÄTEN. Impressum: Medieninhaber und Hersteller: Hartlauer Handelsgesellschaft m b H Stadtplatz 13 4400 Steyr; Verlags und Herstellungsort: 4400 Steyr
Passbilder für Ihren neuen Reisepass, e-Card, Ausweise oder Bewerbungsfotos Passbilder in Studioqualität! Keine Termin vereinbarung nötig! nStudioqualitä S rtzum Mitneh n GARANTIERTE ANNAHME BEI ALLEN ÄMTERN Hartlauer Ruck Zuck Fotobuch –in nur 5 Minuten in der App gestalten Mehr auf hartlauer.at/ruckzuck Foto World Software kostenlos downloaden! hartlauer.at/bestellsoftware Effektvolle Veredelungen Silber Gold Effektlack Roségold Einfach MEHR Weihnachtsfreude! Schenken Sie Freude, die in Erinnerung bleibt.
Kalender